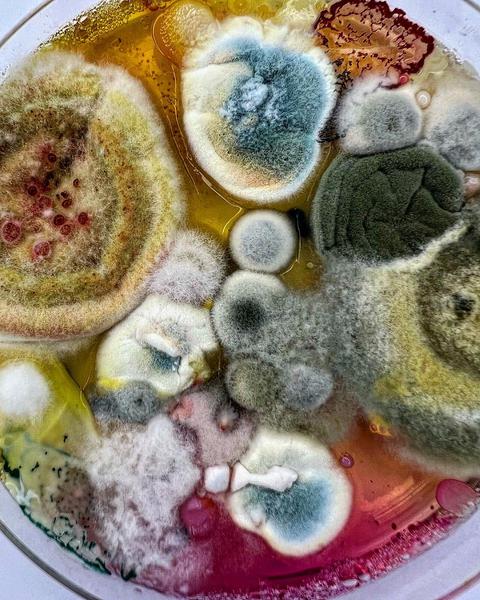

Sobre a “arte” do piropo e a masculinidade tóxica
O mundo seria um lugar melhor se não se fizessem piropos. O céu seria mais azul, os jardins mais floridos e as ruas um local mais seguro. Mas há certas coisas que não mudam da noite para o dia e eu, cá para mim, contento-me com pequenas vitórias.